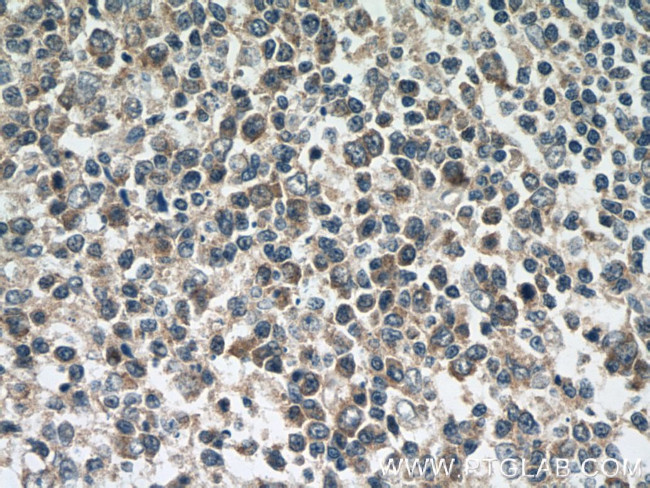
CCL18/MIP-4 Antibody in Immunohistochemistry (Paraffin) (IHC (P))
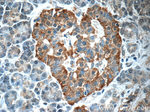
CCL18/MIP-4 Antibody in Immunohistochemistry (Paraffin) (IHC (P))

Search
Proteintech
CCL18/MIP-4 Polyclonal Antibody
{{$productOrderCtrl.translations['antibody.pdp.commerceCard.promotion.promotions']}}
{{$productOrderCtrl.translations['antibody.pdp.commerceCard.promotion.viewpromo']}}
{{$productOrderCtrl.translations['antibody.pdp.commerceCard.promotion.promocode']}}: {{promo.promoCode}} {{promo.promoTitle}} {{promo.promoDescription}}. {{$productOrderCtrl.translations['antibody.pdp.commerceCard.promotion.learnmore']}}
产品信息
22303-1-AP
种属反应
已发表种属
宿主/亚型
分类
类型
抗原
偶联物
形式
浓度
规格
纯化类型
保存液
内含物
保存条件
运输条件
靶标信息
Macrophage Inflammatory Protein-4 (MIP-4), also called CCL18, is a chemokine expressed in the lymph nodes, lungs, placenta and bone marrow. Although the MIP-4s receptor remains undetermined, MIP-4 is known to act as a chemoattractant for activated and non-activated T cells.
仅用于科研。不用于诊断过程。未经明确授权不得转售。
生物信息学
蛋白别名: Alternative macrophage activation-associated CC chemokine 1; AMAC-1; C-C motif chemokine 18; CC chemokine ligand 18; CC chemokine PARC; CCL18; chemokine (C-C motif) ligand 18 (pulmonary and activation-regulated); chemokine (C-C), dendritic; DC-CK1; Dendritic cell chemokine 1; H-MIP-4; Macrophage inflammatory protein 4; MIP-4; Pulmonary and activation-regulated chemokine; small inducible cytokine A18; small inducible cytokine subfamily A (Cys-Cys), member 18, pulmonary and activation-regulated; Small-inducible cytokine A18
基因别名: AMAC-1; AMAC1; CCL18; CKb7; DC-CK1; DCCK1; MIP-4; MIP4; PARC; SCYA18
UniProt ID: (Human) P55774
Entrez Gene ID: (Human) 6362